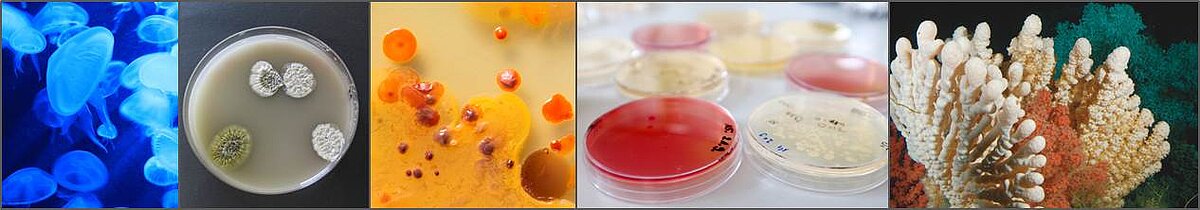

GEOMAR-Biotech ist der Nachfolger des Kieler Wirkstoff-Zentrums KiWiZ, das auf Initiative des Bundeslandes Schleswig-Holstein gegründet wurde. Die Landesregierung finanzierte die Einrichtung der Labore, Anschaffung von Instrumenten und die Einstellung wissenschaftlicher Mitarbeiter im Bereich Marine Naturstoffe (2005-2010). Später förderte sie auch den Aufbau einer Bibliothek zu marinen Naturstoffen durch das KiWiZ (2008-2011).
Nach Bewilligung der Finanzierung im Dezember 2005 wurde das KiWiZ Teil der Forschungseinheit Marine Mikrobiologie am damaligen IFM-GEOMAR und begann seine Arbeit in der angewandten Wissenschaft und Forschung. 2006 zog das KiWiZ um in die Räume am Kiel-Kanal 44, wo unter der Leitung von Professor Johannes F. Imhoff vorranging im Bereich der mikrobialen marinen Naturstoffen geforscht wurde.
2014 konnte Frau Professor Deniz Tasdemir im Rahmen der Helmholtz Recruitment-Initiative für die Leitung des KiWiZ gewonnen werden. Als Teil der neugegründeten Forschungseinheit Marine Naturstoffchemie firmiert das KiWiZ seit 1. Oktober 2015 unter neuem Namen (GEOMAR-Biotech) und mit überarbeitetem Logo. Seit Oktober 2023 befindet sich der Sitz im Neubau des GEOMAR Campus, Wischhofstraße 1 - 3, 24148 Kiel.